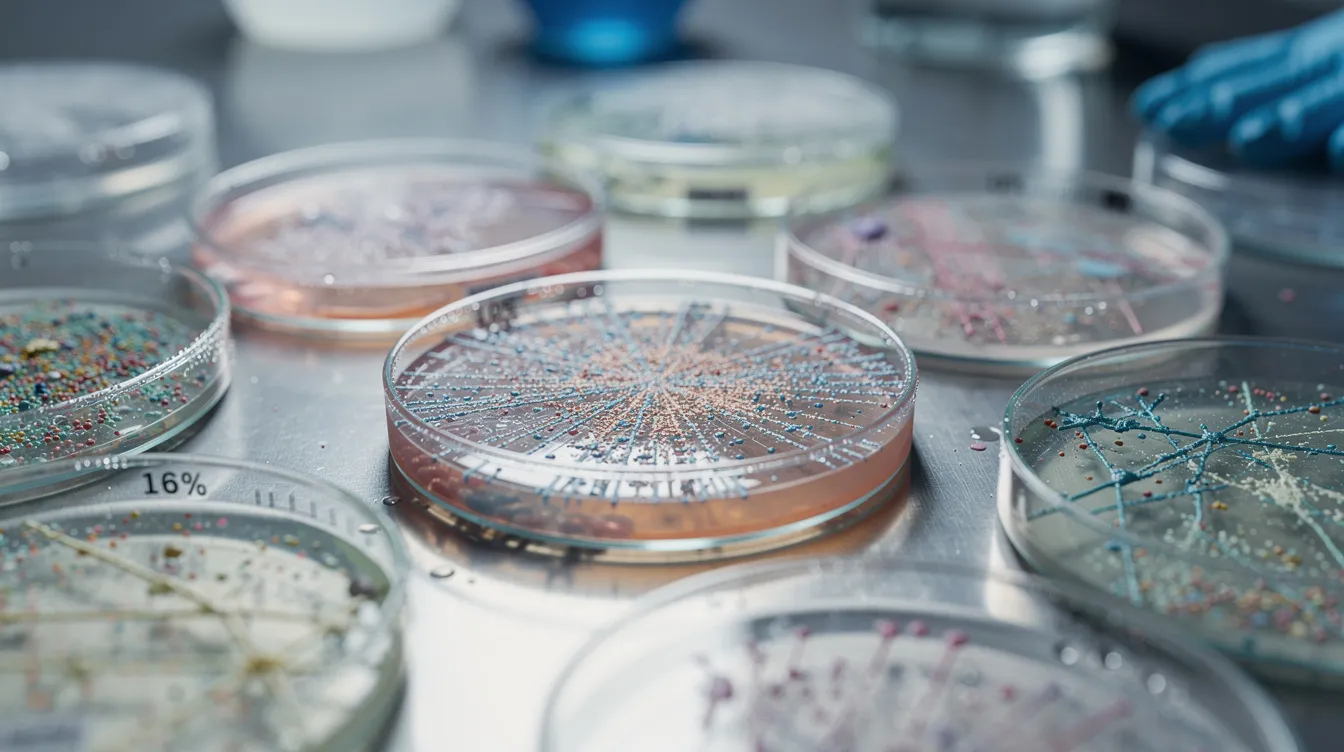
The image features a close-up view of laboratory petri dishes containing various cellular cultures, showcasing the intricate details of the cells. This setting highlights the importance of cellular energy production and research related to nicotinamide mononucleotide (NMN) and its potential benefits in enhancing health and energy levels.

Related topic: This article is part of Head-to-Head Protocol Comparisons. If you want the broader overview, start with Compare Longevity Protocols: Practical Framework For Low-Risk Biohacking. Nicotinamide mononucleotide nmn has emerged as one of the most researched anti aging molecule compounds in longevity science. As a direct precursor to nicotinamide adenine dinucleotide (NAD+), NMN plays a critical role in cellular energy production, dna repair, and sirtuin activation—all processes that decline with age.
But here’s the question that divides supplement users: does liposomal nmn actually outperform powdered nmn and standard nmn capsules?
This guide breaks down the evidence comparing nmn delivery methods, helping you answer:
- Does liposomal encapsulation truly enhance nmn absorption in humans?
- How do cost, stability, and dosing flexibility compare across formats?
- Which delivery method aligns best with your specific health goals?
- How can you measure whether your chosen format is actually working?
NMN Absorption Mechanisms And Delivery Method
Understanding how your human body absorbs NMN helps clarify why delivery method debates exist in the first place. One of the key factors in NMN absorption is ‘bioavailability,’ which refers to the proportion of NMN that enters the circulation and is available for use by the body.
The Slc12a8 Transporter
Recent research identified the Slc12a8 transporter as a specific NMN uptake protein highly expressed in the small intestine. This transporter enables direct nmn absorption into intestinal cells without requiring conversion to nicotinamide riboside first.
Mouse studies demonstrate plasma NMN peaks within 2.5 to 10 minutes post-ingestion—remarkably rapid absorption that challenges assumptions about needing protective encapsulation.
First-Pass Metabolism
After gastrointestinal absorption, NMN travels to the liver where first-pass metabolism occurs. Here, enzymes can convert NMN to nicotinamide, potentially reducing available NMN but still contributing to NAD+ pools.
Gut Microbiome Influence
Your digestive system harbors bacteria that can metabolize NMN precursors. Individual microbiota composition creates variability in overall bioavailability—one reason identical doses produce different results across users.
Liposomal NMN: What To Cover
Liposomal formulations represent a specialized drug delivery approach borrowed from pharmaceutical applications. In liposomal NMN, the NMN molecule is encapsulated within a phospholipid bilayer, which enhances its stability and absorption compared to standard powder forms.
Defining Liposomal NMN Formulation
Liposomal nmn encases NMN molecules within phospholipid bilayers—tiny fat-based spheres that mimic cell membranes. These liposomes are designed to:
- Shield NMN from stomach acid degradation
- Protect against enzymatic breakdown
- Allow direct fusion with intestinal cell membranes
- Bypass reliance on the Slc12a8 transporter
Proposed Absorption Advantages
Proponents claim liposomal technology delivers 3-5 times greater bioavailability than regular nmn. One study on healthy middle aged adults reported an 83% increase in nad levels over 4 weeks with liposomal delivery, with effects persisting 4 weeks post-supplementation.
Christopher Shade, Ph.D., argues that intact liposomes circulate as nano-packages, enhancing cellular uptake beyond what free NMN achieves. Some advanced liposomal NMN products use nanoemulsion technology to further improve absorption.
Stability And Storage Concerns
Here’s where liposomal versions face challenges:
| Concern | Impact |
|---|---|
| Aqueous degradation | NMN degrades quickly in liquid environments |
| Storage requirements | Requires cool, dry conditions |
| Potency loss | 20-50% degradation risk if improperly stored |
| Effective formats | Only lyophilized powder or capsule forms remain stable |
Liquid or gel liposomal forms may be ineffective unless properly processed into dry formats.
Powder And Capsule Form: NMN Capsules And Capsule Form
Standard oral nmn formats have generated the majority of clinical evidence supporting NMN supplementation. Among these, bulk powder is the most economical option for NMN supplementation.
Powder Administration Options
Nmn powder offers flexibility that other formats cannot match:
- Mix into liquids or food
- Custom dose titration for individual needs
- Sublingual dissolution under the tongue
- Bypasses gastric acid via mucosal rapid absorption
Standard Capsule Benefits
The capsule form provides convenience with consistent dosing. However, standard oral capsules face potential degradation from stomach acid unless specifically designed to resist it.
Enteric And Delayed-Release Variants
Patented acid-resistant capsules target small intestine delivery, aligning with where Slc12a8 expression is highest for optimal uptake. This approach addresses gastric degradation concerns while maintaining oral administration convenience.
Delivery Method Variants: Sublingual, Lozenges, Capsules, IV
Beyond standard formats, several alternative delivery methods exist.
Sublingual Delivery
Sublingual nmn involves dissolving powder or lozenges under the tongue. This sublingual route claims superior absorption by:
- Avoiding gastric acid entirely
- Achieving direct bloodstream entry via mucosal tissue
- Completing absorption in 1-5 minutes
Some sublingual formulations add erythritol as a catalyst to enhance sublingual absorption.
Lozenge Format
Lozenges leverage slow dissolution for prolonged mucosal exposure. This sublingual administration approach extends contact time with absorptive tissue, potentially improving uptake compared to rapid sublingual powder dissolution.
Intranasal Sprays
Intranasal nmn delivery remains experimental with minimal data supporting its effectiveness. This format bypasses the digestive system entirely but lacks clinical validation.
Intravenous Administration
IV NMN achieves near-100% bioavailability by bypassing all absorption barriers. However, this delivery method:
- Requires clinical settings
- Carries infection risks
- Remains uncommon and impractical for routine nmn supplementation

NMN Dosage, Clinical Trials, And Reported Benefits
Clinical trials provide the foundation for understanding effective nmn dosage and real-world nmn benefits.
Clinical Trial Dosing Ranges
Most dose dependent clinical trial research uses standard powder or capsule forms at these ranges:
| Daily Dose | Study Population | Key Finding |
|---|---|---|
| 100-300 mg | General adults | Elevated NAD+ levels |
| 250 mg/day | Adults (60 days) | 40% NAD+ increase in blood |
| 300 mg/day | Older adults | Improved 6-minute walk test |
| 300-900 mg | Prediabetic women | Improved muscle insulin sensitivity |
| Up to 1200 mg | Various trials | Safe with dose-dependent effects |
Reported NMN Benefits
Taking nmn supplements has been associated with:
- Increased energy levels and energy production
- Enhanced physical performance
- Improved vascular and human health markers
- Better sleep quality
- Reduced biological aging markers (DNA methylation clocks)
- Cognitive function support
- Potential benefits for age related diseases
Evidence Gaps
Here’s the critical limitation: no major clinical trials directly compare liposomal delivery against powder or capsule forms measuring pharmacokinetics and outcomes side by side. The 83% NAD+ increase study with liposomal NMN lacks direct comparison arms against standard formats.
Most research establishing nmn benefits relies on non-liposomal forms, leaving enhanced bioavailability claims largely theoretical.
Comparing Bioavailability: Liposomal NMN Vs Powder Vs Capsules
How do these delivery methods actually stack up? The ultimate goal is to maximize the amount of NMN reaching systemic circulation, ensuring the compound is effectively absorbed into the bloodstream.
Claimed Bioavailability Comparison
| Format | Claimed Advantage | Evidence Quality |
|---|---|---|
| Liposomal NMN | 3-5x superior absorption via cellular fusion | Preliminary, mostly preclinical |
| Sublingual powder | Rapid mucosal absorption, bypasses digestion | Expert speculation, limited trials |
| Standard capsule | Convenient, forms bulk of research base | Strong clinical trial support |
| Enteric-coated capsule | Targeted small intestine delivery | Mechanistically sound, emerging data |
Evaluating The Evidence
Liposomal NMN: One study showed liposomal outperforming standard NMN in NAD+ elevation, but peer-reviewed evidence remains preliminary. Large RCTs confirming superior absorption claims don’t exist yet.
Standard Powder/Capsules: Demonstrated rapid absorption with plasma peaks in minutes. These formats generated the vast majority of positive nmn research outcomes.
Sublingual Formulations: May match liposomal effects according to some experts, but confirmatory data is absent. The sublingual route avoids first-pass metabolism theoretically, but human trials measuring this advantage are sparse.
What Future Trials Need
Direct clinical comparisons should measure:
- NAD+ pharmacokinetics across formats
- Dose-response curves by delivery method
- Outcomes like insulin sensitivity and physical performance
- Cost-benefit analyses for each format
Until these trials exist, choosing based on theoretical superior absorption remains speculative.
Practical Considerations: Cost, Stability, And Health Goals
Beyond bioavailability debates, practical factors influence which format serves you best.
Cost Comparison
| Format | Typical Cost Per mg | Notes |
|---|---|---|
| Powdered nmn | $0.10-0.30 | Most economical, bulk options available |
| Standard capsules | $0.15-0.40 | Mid-range, convenient |
| Liposomal NMN | $0.50-1.00 | 2-5x pricier due to encapsulation tech |
If liposomal truly delivers 3-5x bioavailability, smaller effective doses could offset higher costs. Without proven absorption advantages, the premium may not justify itself.
Shelf-Life And Storage
Dry powders and capsules: 2+ years at room temperature when stored properly
Liposomal products: Sensitive to heat and moisture, risking 20-50% potency loss if improperly stored. Require cool, dry conditions consistently.
For users in warm climates or without controlled storage, powder stability offers clear advantages.
Matching Format To Health Goals
| Health Goal | Recommended Format | Reasoning |
|---|---|---|
| Metabolic/cognitive support | Research-backed capsules | Strongest clinical evidence base |
| Absorption concerns (gut issues) | Liposomal or sublingual | Bypasses digestive system |
| Budget-conscious | Powder | Lowest cost, flexible dosing |
| Higher doses needed | Powder | Cost-effective at scale |
| Convenience priority | Capsules | No measuring required |

How To Choose: Match Delivery Method To Health Goals
Here’s how to select the right nmn dosage format based on your priorities.
Choose Capsule Form If You Value:
- Convenience and consistent dosing
- Formats with the strongest clinical trial backing
- Intestine-targeted delivery (especially enteric-coated)
- No preparation or measurement required
This option suits most users seeking reliable oral supplementation without complexity.
Choose Liposomal NMN If You:
- Prioritize potential absorption advantages despite limited evidence
- Have digestive issues affecting nutrient uptake
- Accept higher costs for theoretical liposomal delivery benefits
- Want formats that may reduce dose requirements
Understand that you’re paying a premium for mechanistic plausibility rather than proven outcomes.
Choose Powder If You:
- Need dosing precision and flexibility
- Are cost-conscious or require higher doses
- Want to experiment with sublingual delivery
- Prefer mixing with food or beverages
The starting dose flexibility powder offers helps your body adjusts gradually. You can gradually increase amounts based on response.
Consult A Healthcare Professional
Before taking nmn supplements at any dose, especially at higher doses, consulting a healthcare provider helps identify any safety concerns specific to your situation. Those in integrative medicine may have particular familiarity with nmn supplementation protocols.
Measure Results: NAD+ Testing And Clinical Evidence
Don’t rely on subjective feelings alone. Here’s how to track whether your chosen format works.
Baseline NAD+ Testing
Before starting oral supplementation, get baseline NAD+ levels measured through blood intracellular assays (mass spectrometry-based tests). This establishes your starting point.
Retest After 4-8 Weeks
Following dose changes or format switches, retest at 4-8 weeks. Clinical trials report NAD+ elevations of 20-80% depending on dose and individual response.
Use Clinical Endpoints As Guides
Beyond NAD+ levels, consider tracking markers that correlate with trial endpoints:
- Grip strength measurements
- HbA1c levels (for metabolic function)
- Physical performance metrics
- Energy level patterns
- Taking supplements on empty stomach vs with food and noting differences
Research from yi l and others supports placebo controlled trial endpoints as meaningful benchmarks.
Figures like David Sinclair have popularized NAD+ tracking, but individual responses vary regardless of which nmn supplements you choose.
Summary Recommendation And Next Steps
The evidence supports a clear hierarchy when selecting NMN delivery methods.
Prioritize Consistent Dosing
The optimal dosage taken consistently matters more than theoretical delivery advantages. Finding the right nmn dosage (typically 250-500 mg/day based on trials) and maintaining it produces better outcomes than chasing unproven absorption claims at lower doses.
Clinical Guidance
Clinicians should reference trials when recommending nmn dosage—these predominantly use standard oral powders and capsules, not liposomal versions. The health benefits demonstrated come from these formats.
What’s Needed Next
Future RCTs should provide:
- Pharmacokinetic profiling across delivery methods
- Comparative efficacy on aging biomarkers
- Cost-benefit analyses per format
- Long-term safety data beyond 1 year
Until direct comparisons exist, the potential benefits of liposomal encapsulation remain theoretical. Choose the format that fits your budget, lifestyle, and consistency ability—then measure your results.
Related reading
- Compare Longevity Protocols: Practical Framework For Low-Risk Biohacking
- NMN vs NR: Nicotinamide Mononucleotide Versus Nicotinamide Riboside
- Huberman Vs Sinclair Protocol: Comparing Approaches To The Biology Of Slowing & Reversing Aging
- Comparing the Sinclair vs Attia Protocol: Longevity and Healthspan Approaches



